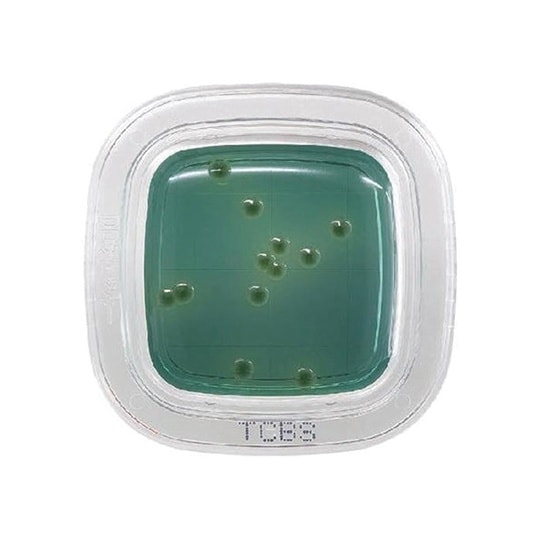
【冷蔵】ぺたんチェックDD TCBS寒天培地 1

入数 1箱 販売価格 ¥3,344 (税込)
分析/検査用品の売れ筋ランキング
- ¥606(税込) (税込) 〜
- ¥491(税込) (税込) 〜
- ¥4,510(税込) (税込) 〜
4位
 アズワン 定性濾紙
アズワン 定性濾紙
- ¥438(税込) (税込) 〜
5位
 pH試験紙 ロールタイプ
pH試験紙 ロールタイプ
- ¥1,881(税込) (税込) 〜
6位
 pH標準液
pH標準液
- ¥1,430(税込) (税込) 〜
- ¥10,972(税込) (税込) 〜
商品の特徴 |
ぺたんと押して微生物チェックします。特定の汚染菌の有無を選択的に確認できます。一般細菌検出用培地は最短8時間で判定が可能です(発色液を使用)。 |
|---|---|
商品仕様 |
|
メーカー情報 |
|
カタログ掲載ページ |
-/- |
| 注意事項 | ※【お届けに関するご注意】この商品は、画面に表示されているお届け予定日までにお届けいたします。実際のお届けが、予定日よりも早まる場合がございます。【返品に関するご注意】この商品は直送品のため、お客様のご都合による返品はお受けできません。 |
|---|